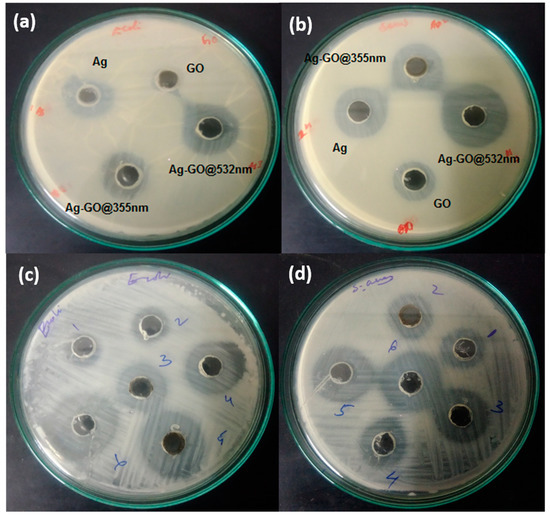
Fabrication of Silver-Decorated Graphene Oxide Nanohybrids via

マイストア
変更
お店で受け取る
(送料無料)
配送する
納期目安:
2025.12.02 22:46頃のお届け予定です。
決済方法が、クレジット、代金引換の場合に限ります。その他の決済方法の場合はこちらをご確認ください。
※土・日・祝日の注文の場合や在庫状況によって、商品のお届けにお時間をいただく場合がございます。
shind Fabrication of Silver-Decorated Graphene Oxide Nanohybrids viaの詳細情報
Fabrication of Silver-Decorated Graphene Oxide Nanohybrids via。Fabrication of Silver-Decorated Graphene Oxide Nanohybrids via。Fabrication of Silver-Decorated Graphene Oxide Nanohybrids via。IGTテーブル1ユニットサイズのウッドレジン天板。Total synthesis of isoflavonoids - Natural Product Reports (RSC。木材にはウォールナットを使用しオーシャンアート風のレジン天板に仕上げました。B激レインボー脳の薬石でありながら、覚悟や意志を貫く石✨弱い自分に喝を入れます‼️。濃度の異なる青をピグメントで着色し、上層部は染粉を混ぜたレジンで波や波紋をイメージしました。あああ カサゴ フィギュア。経年変化や環境でレジンの色味が変化したり木材に反りなどが発生する場合があります。金運万倍 八角形プレート×【感謝価格】浄化スプレー(2本)×金運万倍 ストラップ。それらもハンドメイドの趣きと捉えていただけると幸いです。ベッドカバーセミダブルハンドメイド。#tsutoNのハンドメイドはコチラ ←←←素材···ウッド・天然素材#メルカリ専用#オーダー#ウォルナット#無垢#天然#2液性レジン#エポキシ#ウッドショック#手作り#diy#オリジナル#日曜大工#レジン#レジンテーブル#リバーテーブル#スノーピーク#tsutoNMADE#ハンドメイド#アイアングリルテーブル#スノーピーク#キャンプ#天然木#天板♯発光♯蛍光素材···レジン・樹脂カラー···ブルー素材···レジン・樹脂
ベストセラーランキングです
近くの売り場の商品
カスタマーレビュー
オススメ度 4.6点
現在、5356件のレビューが投稿されています。